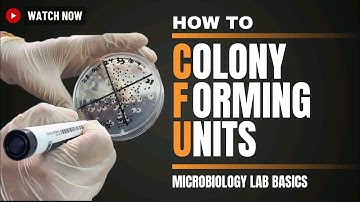
Colony Forming Units (CFUs) in Microbiology: Estimating Bacterial Concentrations | Microbiology Lab

⬇ DOWNLOAD NOW
Kalau muncul iklan pop-up, tutup lalu klik tombol kembali
Download lagu Calculating Number of Bacterial Cells secara gratis hanya untuk keperluan promosi. Dukung artis favorit kamu dengan membeli musik original di iTunes atau platform resmi lainnya.
 Bacteria_Number of Cells
Bacteria_Number of Cells
 Bacterial Growth Curve & Generation time Calculation
Bacterial Growth Curve & Generation time Calculation
 How to Calculate CFU per ml of Bacterial Sample? in 3 Steps || cfu/ml in Microbiology
How to Calculate CFU per ml of Bacterial Sample? in 3 Steps || cfu/ml in Microbiology
 Counting Cells with a Hemocytometer
Counting Cells with a Hemocytometer
 Measurement of Bacterial Growth: Microbio Pre-Nursing, Pre-Med & Health Field Careers | @LevelUpRN
Measurement of Bacterial Growth: Microbio Pre-Nursing, Pre-Med & Health Field Careers | @LevelUpRN
 Viable Cell Count Results
Viable Cell Count Results
 Hoe bereken je de generatietijd van bacteriën? ||Microbiologie
Hoe bereken je de generatietijd van bacteriën? ||Microbiologie
Colony Forming Units (CFUs) in Microbiology: Estimating Bacterial Concentrations | Microbiology Lab
Colony Forming Units (CFUs) in Microbiology: Estimating Bacterial Concentrations | Microbiology Lab